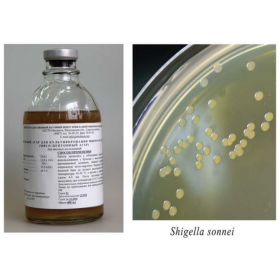
Мясо-пептонный агар 200 мл

Мясо-пептонный агар 200 мл
Мясо-пептонный агар готовый к применению 200 мл
Питательная среда для культивирования при бактериологическом исследовании различных микроорганизмов, включая: энтеробактерии, псевдомонады, стафилококки.
Данный продукт предназначен для исследовательских целей.
Срок годности 1 год.
- Стерильность: +
- Форма выпуска: Порошок
- Упаковка: 200 мл
- Документы: Для исследовательских целей